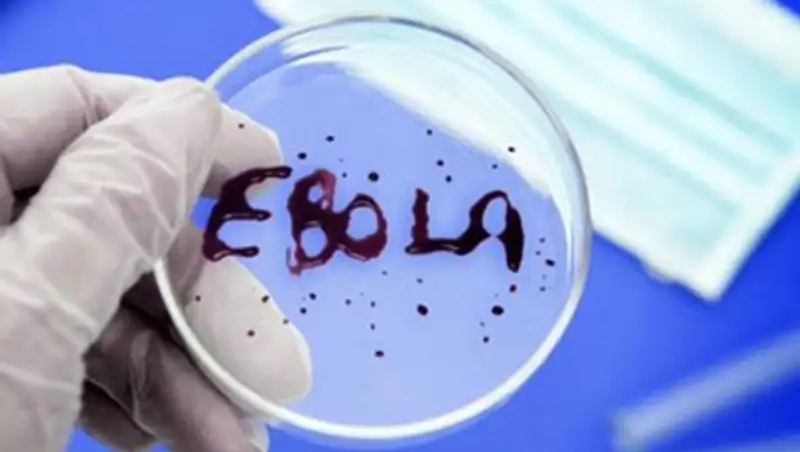
В Казахстане не требуется создания спецструктуры по борьбе с Эболой - Минздрав

В Казахстане обсуждают план поэтапной борьбы с ящуром
 Zakon.kz
Zakon.kz
Распространение этой вирусной болезни животных может нанести огромный урон сельскому хозяйству, торговле и экономикам стран мира.
Делегаты Международного эпизоотического бюро (МЭБ) и национальные координаторы по ящуру из 14 стран обсудили в Алматы План поэтапной борьбы с ящуром в странах мира, сообщает Zakon.kz со ссылкой на пресс-службу МСХ РК.
Этот документ разработан экспертами Продовольственной сельскохозяйственной организации ООН (ФАО) и МЭБ в рамках оказания помощи в разработке национальных программ контроля по борьбе с ящуром для тех стран, где ящур является эндемическим заболеванием.
По данным Международного эпизоотического бюро, ежегодно до 70 стран становятся неблагополучными по ящуру.
Распространение этой вирусной болезни животных может нанести огромный урон сельскому хозяйству, торговле и экономикам стран мира.
В заседании участвуют делегаты МЭБ и национальные координаторы по ящуру из 14 стран мира, в т.ч. Афганистана, Армении, Азербайджана, Грузии, Казахстана, Кыргызстана, Ирака, Ирана, Пакистана, России, Сирии, Таджикистана, Турции, Туркменистана, Узбекистана.
Также на Шестом заседании по Дорожной карте ящура в Западной Евразии участники представили разработанный План поэтапной борьбы с ящуром в МЭБ для утверждения с целью улучшения эпизоотической ситуации по ящуру и возможности в дальнейшем получения статуса благополучной территории.
Помимо этого стороны обменялись информацией о циркуляции вируса ящура в экосистеме Западной Евразии.
Отметим, что ящур – особо опасная вирусная болезнь парнокопытных животных, характеризующаяся острым течением, высоким процентом заболеваемости восприимчивых животных, высокой скоростью распространения и проявляющаяся клинически афтозными поражениями слизистой оболочки ротовой полости и кожи венчика копыт.
Поделитесь новостью
Астана
Грузия
Азербайджан
Актау
Актобе
Алматы
Армения
Афганистан
Ирак
Иран
Казахстан
Кызылорда
Кыргызстан
Пакистан
Семей
Сирия
Таджикистан
Туркменистан
Турция
Узбекистан
Читайте также
Если вы видите данное сообщение, значит возникли проблемы с работой системы комментариев. Возможно у вас отключен JavaScript